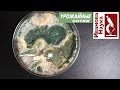

ГДЕ САЖАТЬ БУДЛЕЮ
Будлея, или Будлейя, является популярным растением в садоводстве и сельском хозяйстве. Она привлекает внимание своими яркими и ароматными цветами, а также способностью привлекать бабочек и других полезных насекомых.
При выборе места для посадки будлеи, важно учесть ее особенности и требования. Обычно будлея предпочитает солнечное положение, поэтому лучше всего сажать ее на открытых и хорошо освещенных участках. Тем не менее, в некоторых регионах ее также можно выращивать в полутени.
Важно выбрать хорошо дренированный грунт, богатый органическим материалом. Будлея не любит затопленных участков и переувлажнения, поэтому стоит избегать садовых углублений или мест, где вода может задерживаться.
Поскольку будлея вырастает в достаточно крупное растение, необходимо обеспечить ей достаточно места для распространения. Рекомендуется соблюдать интервалы в 1,5-2 метра между растениями, чтобы они имели достаточно света и воздуха для роста.
В целом, будлею можно сажать в различных условиях, но придерживаясь указанных рекомендаций по положению солнца, грунту и пространству между растениями, можно обеспечить ей благоприятные условия для роста и развития, что позволит получить красивые и здоровые растения.
Почему гибнет Буддлея ✔️ Как выбрать саженцы Буддлеи
САМЫЙ НЕПРИХОТЛИВЫЙ КУСТАРНИК В САДУ - БУДЛЕЯ
10 секретов выращивания дельфиниума из семян
Буддлея Давида - хлопотно или красиво? Стоит ли сажать? Игорь Билевич
Как вырастить красивую будлею.
Секреты успеха по уходу за буддлеей Давида ! Buddleja Davidii
Буддлея Давида из семян. И стоит ли сажать её на своём участке.
Цветы будлея – посадка и уход; выращивание будлеи из семян; размножение будлеи Давида